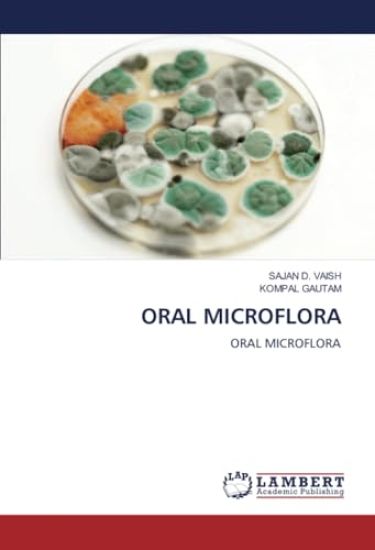
Oral Microflora

Kirjahaku
Etsi kirjoja tekijän nimen, kirjan nimen tai ISBN:n perusteella.
1000 tulosta hakusanalla Oral Sumner Coad


Oral health in a women's prison unit
Mara Ilka H de Medeiros Batista; Marcília Ribeiro Paulino; Alessandra de a Tavares Carvalho

Oral Genodermatoses
Shaik Mobeen; Nalluri Meghana; Nimmy Fernandez

Oral Functionality in Edentulous Patients
Diptesh Rami; Rajesh Sethuraman; Bhagyashree Sutaria

Oral Health Considerations in the Aging Population
Manu Rathee; Pritish Dixit; Sarthak Singh Tomar

Oral Manifestations and Complications of Diabetes Mellitus
Sayali Sisodiya; Ajay Bhoosreddy; Chetan Bhadage

Oral Health Status and Treatment Needs of Sensory Deficits Children
Pallavi Katkam; Manjunath P Puranik; Namita Shanbhag

Oral and Maxillofacial Trauma in Pediatric Patients
Priyal Fadia; Vasudha Sodani; Devdatt Sharma

Oral mucosal lesions
Adlin Alvelo Chacón; Yadira Hernández Sosa; Addinay Trujillo Rodríguez


Oral Health Status and Oral Health Related Quality of Life
Kadeejathul Shahazia; Rekha Shenoy

Oral Hygiene and the Interrelationship with Cardiovascular Diseases
Sardorbek Bobojonov

Oral Health Care for Refugees
Badmanaban Krishna Murthy; Manjunath P Puranik; Sowmya K R

ORAL SURGERY in PEDIATRIC DENTISTRY
Parita Gadhia; Ruchi Arora

Oral Lesion Associated with Covid-19
Gargi Rathod; Monali Shah; Amena Ranginwala

Oral candidiasis in diabetics
Ouanassa Hamouda; Nabila Kalla; Ahlem Merzougui


Oral Health
Jesse Steve Sarmiento; David Cristiano Jiménez; Carlos Alexander Mendoza Jacomino

